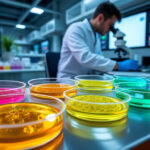
découvrez comment les biotechnologies transforment la création et l’utilisation des levures hybrides, en favorisant l’innovation dans l’agroalimentaire, la fermentation et l’industrie pharmaceutique.

Dans un monde où les avancées technologiques s’invitent de plus en plus dans les objets du quotidien, les verres connectés émergent comme un exemple probant d’intégration entre optique traditionnelle et innovation numérique. Cette innovation sensorielle offre non seulement des perspectives inédites pour améliorer la vision et la santé, mais redéfinit également notre interaction avec l’univers numérique. Grâce à des marques emblématiques telles que EssilorLuxottica, Ray-Ban Stories ou encore JINS Meme, la lunetterie connectée est en train de prendre un tournant décisif. Cet article s’attarde sur les caractéristiques avancées des verres connectés, leurs applications pratiques, mais aussi les défis techniques et éthiques liés à cette technologie révolutionnaire.
Les avancées technologiques majeures derrière les verres connectés
Les verres connectés représentent une hybridation réussie entre optique et électronique embarquée. Dès les premiers prototypes, des sociétés telles que Google et Vuzix ont introduit des micro-écrans et des capteurs intégrés aux verres, permettant de projeter des informations en temps réel sans gêner la correction visuelle. Cette fusion technologique s’appuie sur des composants miniaturisés et sur des innovations dans les matériaux pour maintenir un équilibre optimal entre confort, fonctionnalité et esthétique.
Parmi les principales innovations, il est important de souligner :
- Affichage tête haute (HUD) : une technologie qui superpose des éléments d’interface directement dans le champ de vision sans bloquer la perception du monde réel.
- Sensibilités aux capteurs biométriques : la mesure de la fréquence cardiaque, de la qualité du sommeil, ou même des variations de stress fournit des données essentielles pour le suivi de la santé.
- Connectivité fluide : via Bluetooth ou Wi-Fi, les verres se synchronisent avec divers appareils, assurant une expérience connectée complète et instantanée.
Des modèles tels que les Bose Frames ou les Huawei Eyewear sont des exemples concrets de cette tendance, proposant des lunettes au design contemporain avec des fonctions audio, d’appel ou de commandes vocales intégrées.
| Technologie | Fonctionnalité | Exemple de marque | Application principale |
|---|---|---|---|
| Micro-écran OLED | Affichage HUD, notifications | Ray-Ban Stories | Affichage en temps réel d’informations |
| Capteurs biométriques | Surveillance santé, fréquence cardiaque | JINS Meme | Suivi de bien-être et activité sportive |
| Bluetooth et Wi-Fi | Connectivité smartphone | Huawei Eyewear | Appels, musique, commandes vocales |
| Audio intégré | Appels et musique | Bose Frames | Expérience sonore immersive sans casque |
Ces avancées attestent que les verres connectés enrichissent très concrètement le champ des possibles en cette année 2025.
Usage et applications innovantes des verres connectés dans la vie quotidienne et professionnelle
Au-delà de l’aspect technologique, la véritable valeur des verres connectés réside dans leurs applications pratiques. Dans la vie quotidienne, ils apportent un soutien constant, facilitant entre autres :
- La communication discrète : recevoir et gérer appels ou messages sans sortir le smartphone.
- La navigation GPS intégrée, parfait pour les déplacements urbains ou les activités de plein air.
- Le suivi de paramètres santé en temps réel, aidant à mieux gérer la fatigue ou le stress.
Au travail, les lunettes intelligentes apportent une révolution majeure, notamment dans les domaines de l’industrie, de la formation et des services. Par exemple :
- Assistance technique à distance : via des flux vidéo en direct, un expert peut guider un opérateur en temps réel, réduisant ainsi les erreurs et améliorant la productivité.
- Formation immersive : la superposition d’images et d’instructions sur le champ de vision facilite l’apprentissage pratique de tâches complexes.
- Gestion des données terrain : collecte facilitée d’informations et retour instantané grâce à une interface intégrée.
Dans le secteur de la santé, certaines innovations ouvrent aussi des perspectives remarquables : l’intégration des capteurs dans les verres connectés permet d’établir un suivi continu des constantes vitales, un aspect essentiel pour les patients à risques ou les sportifs de haut niveau.
Un exemple illustratif est la collaboration entre Atol Les Opticiens et EssilorLuxottica qui développe des produits alliant correction visuelle personnalisée et technologies connectées pour le bien-être visuel et la santé globale.
| Domaine | Application pratique | Impact |
|---|---|---|
| Industrie | Guidage et assistance à distance | Réduction des erreurs, gain de temps |
| Sport et bien-être | Suivi biométrique et feedback instantané | Optimisation de la performance et prévention |
| Santé | Monitoring continu des signes vitaux | Mieux-être et prévention accrue |
| Vie quotidienne | Notifications et navigation GPS | Fluidité et efficience dans les déplacements |
Les défis à relever pour une adoption massive des verres connectés
L’intégration intensive des technologies dans des verres optiques pose naturellement plusieurs défis techniques, sociaux et éthiques. La sécurité des données personnelles est au cœur des préoccupations, notamment en ce qui concerne les informations biométriques sensibles collectées par les capteurs.
Les risques incluent la piraterie informatique ciblée, qui pourrait porter atteinte à la vie privée. Ainsi, les fabricants comme Rochester Optical et Archos doivent mettre en œuvre des protocoles de chiffrement de pointe pour assurer la confidentialité et la protection des utilisateurs.
Le design et le confort sont également déterminants. Un boîtier trop volumineux ou des verres trop lourds risquent de freiner l’adoption par le grand public. L’équilibre entre fonctionnalité technique et esthétique se veut un enjeu crucial. Le confort d’utilisation au quotidien passe aussi par une autonomie satisfaisante. Les batteries doivent pouvoir soutenir un usage prolongé sans recharges trop fréquentes.
Enfin, l’acceptation sociale reste un facteur de réussite. Certains utilisateurs peuvent percevoir ces lunettes comme intrusives, voire dérangeantes dans leur vie privée. Cela invite à une réflexion approfondie sur l’ergonomie sociale et les aspects réglementaires entourant ces innovations.
- Confidentialité et protection des données.
- Autonomie et résistance des matériaux.
- Poids et confort du port prolongé.
- Accompagnement pédagogique pour l’adaptation aux interfaces.
- Normes légales liées à l’enregistrement vidéo et audio.
Ces défis appellent à une collaboration étroite entre ingénieurs, professionnels de la santé visuelle et législateurs pour que la technologie bénéficie à tous sans compromis majeur.
Contributions des leaders de l’industrie des verres connectés en 2025
Le marché des verres connectés s’est considérablement enrichi grâce à l’implication d’acteurs majeurs. EssilorLuxottica, avec la gamme Ray-Ban Stories, a ouvert la voie à une conception esthétique marquée par des matériaux légers et une intégration discrète des composants électroniques. Par ailleurs, JINS Meme se distingue en proposant des verres spécialisés dans le suivi biométrique précis pour le secteur sportif et médical.
Vuzix et Archos jouent un rôle important dans la diversification des fonctionnalités, allant de l’assistance professionnelle jusqu’à une utilisation plus grand public, tandis que Huawei Eyewear et Bose Frames misent sur une expérience audio immersive avec commandes gestuelles et vocales raffinées.
La collaboration entre ces entreprises illustre une industrialisation progressive et la démocratisation des verres connectés, offrant un choix large et des gammes adaptées aux divers besoins. Ils travaillent par ailleurs à maintenir la compatibilité avec des applications tierces renforçant les usages, dont celles relatives à la santé et au bien-être telles que détaillées sur cette plateforme spécialisée.
| Entreprise | Produit phare | Fonctionnalités clés | Avantage concurrentiel |
|---|---|---|---|
| EssilorLuxottica | Ray-Ban Stories | Affichage HUD, design iconique | Alliance esthétique et technologie |
| JINS Meme | Verres biométriques | Suivi santé et sport | Précision des capteurs |
| Vuzix | Smart Glasses Pro | Assistance professionnelle | Fonctionnalités avancées pour industrie |
| Huawei Eyewear | Audio connecté | Musique et appels sans casque | Expérience utilisateur immersive |
| Bose Frames | Audio lunettes | Son haute qualité, commandes tactiles | Port confortable et design |
Perspectives d’évolution et intégration future des verres connectés
Alors que les premiers pas des verres connectés ont été marqués par des prototypes souvent considérés comme gadgets, 2025 témoigne d’une maturité technologique croissante. L’évolution prochaine de ces dispositifs privilégiera des technologies comme les micro-OLED ultra-fins, une intelligence artificielle embarquée plus puissante, et une adaptation automatique en temps réel à l’environnement visuel et physiologique de l’utilisateur.
Les progrès porteront également sur la miniaturisation pour améliorer simultanément confort et performances. À terme, le but est d’atteindre une symbiose parfaite entre les besoins visuels, sensoriels et communicationnels. Cette innovation promet d’élargir l’accès à une multitude de services notamment dans les domaines suivants :
- Éducation immersive : apprentissage par réalité augmentée superposé.
- Assistance médicale : diagnostic et suivi à distance plus précis.
- Travail collaboratif : partage instantané d’informations visuelles.
- Loisirs numériques : expériences gaming et multimédia enrichies.
Par ailleurs, l’intégration avec des plateformes telles que celles proposées par Oculus (Meta) devrait contribuer à la convergence entre réalité virtuelle et réalité augmentée, rendant cette expérience encore plus immersive et polyvalente.
L’enjeu majeur de cette prochaine phase sera de préserver l’équilibre entre innovation technologique et respect de la vie privée, tout en assurant un accès équitable à ces innovations. Le rôle des professionnels de la filière lunetterie, combiné à une régulation adéquate, sera fondamental pour accompagner cette transformation.
Questions fréquentes sur les verres connectés
- Les verres connectés sont-ils adaptés à toutes les corrections visuelles ?
Oui, grâce à des technologies avancées, ils peuvent intégrer des corrections personnalisées tout en combinant des fonctions numériques. - Quelle est l’autonomie moyenne d’une paire de verres connectés ?
Elle varie selon les modèles mais est généralement comprise entre 6 et 12 heures pour un usage typique. - Comment les données de santé sont-elles protégées ?
Les fabricants appliquent des protocoles de chiffrement robustes et respectent les normes européennes GDPR pour assurer confidentialité et sécurité. - Peut-on utiliser les verres connectés avec un smartphone de n’importe quelle marque ?
La plupart des verres connectés sont compatibles avec les systèmes iOS et Android, mais il est conseillé de vérifier la compatibilité spécifique selon les modèles. - Les lunettes connectées sont-elles intrusives ou gênantes dans la vie sociale ?
Les designs ont beaucoup évolué pour minimiser l’aspect intrusif; toutefois, une adaptation progressive reste nécessaire pour certains utilisateurs.